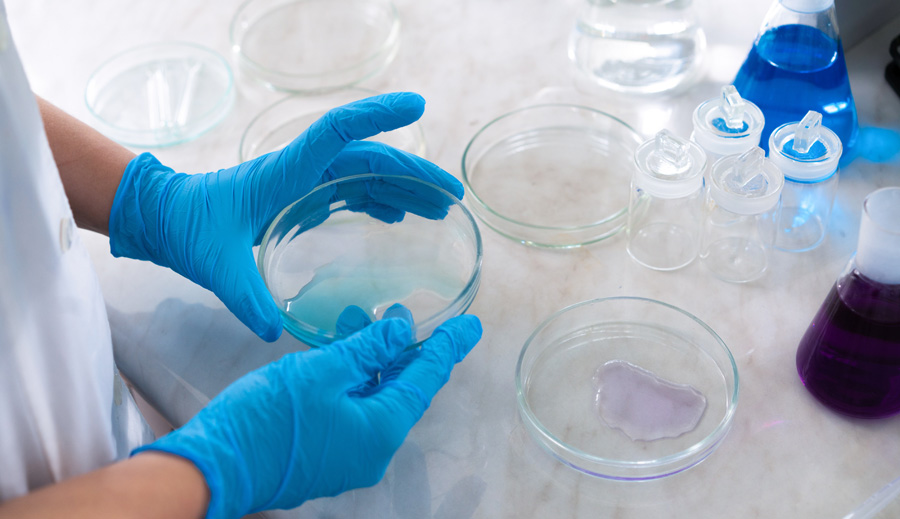

وصفت منظمة الصحة العالمية في تقرير رسمي صدر عنها مؤخراً، "الرغبة المفرطة في ممارسة الجنس" بأنها اضطراب نفسي، ولكنها نفت في الوقت نفسه أن الإفراض في ممارسة الجنس أحد أشكال مستويات الإدمان.
ووفقاً لما نقلته ( BBC )، فقد ظل مصطلح "إدمان الجنس" مثيراً للجدل على مدار عقود، لكن الخبراء اختلفوا بشأن اعتباره حالة مثبتة للإدمان.
واتخذت منظمة الصحة العالمية، في آخر تحديث للقائمة الخاصة بالأمراض والإصابات في جميع أنحاء العالم، خطوة نحو إضفاء شرعية على المفهوم، من خلال الاعتراف بـ"الرغبة المفرطة في ممارسة الجنس" كاضطراب نفسي.
لكن المنظمة التابعة للأمم المتحدة لم تصل إلى وصف هذا السلوك ومساواته بالإدمان مثل تعاطي المخدرات أو القمار، وتصر على ضرورة إجراء المزيد من الأبحاث قبل بلوغه درجة الإدمان.
وقال جيفري ريد، خبير في المنظمة، لوكالة فرانس برس للأنباء يوم السبت :"بلا مبالغة، لا نصل إلى دليل حتى الآن يشير إلى أن العملية تعادل إدمان الكحول أو الهيروين".
وقالت منظمة الصحة العالمية إن الجدل العلمي مازال دائرا بشأن "ما إذا كانت الرغبة المفرطة في ممارسة الجنس يعد ظاهرة لإدمان سلوكي".
وقال ريد إنه من بالغ الأهمية أن يتضمن سجل التصنيف العالمي للأمراض، الذي يستخدم على نطاق واسع كمؤشر للتشخيص وضمان الصحة، تعريفا دقيقا لهذا السلوك الجنسي على نحو يضمن تقديم المساعدة للمتضررين.
وأضاف :"هناك مجموعة من الناس يشعرون أنهم خارج السيطرة فيما يتعلق بسلوكهم الجنسي ويعانون بسبب ذلك"، مشيرا إلى أن سلوكهم الجنسي في بعض الأحيان يكون له "عواقب وخيمة جدا".
ولايزال غير واضح كم عدد من يعانون من هذا الاضطراب، وقال ريد إن قائمة التصنيف العالمي للأمراض من المحتمل أن تؤدي إلى إجراء مزيد من البحث في الحالة وانتشارها، وكذلك في تحديد العلاجات الأكثر فعالية.
وأضاف ريد :"ربما سنقول في النهاية نعم، إنه إدمان، لكن هذا ليس في مرحلتنا هذه".
وازداد الحديث عن مزاعم "إدمان الجنس" في عناوين الصحف الرئيسية تزامنا مع انطلاق حركة "أنا أيضا" في شتى أرجاء العالم لمناهضة التحرش الجنسي.
وتسببت هذه الانتفاضة في سقوط رجال أقوياء في مختلف القطاعات، بما في ذلك عملاق الإنتاج السينمائي في هوليوود، هارفي واينستين، الذي يقال إنه قضى شهورا في العلاج من إدمان الجنس.
وقال ريد إنه لا يعتقد أنه سيكون هناك مخاوف من استخدام القائمة الجديدة من جانب أناس مثل واينستين لتبرير سلوكيات إجرامية مزعومة.
وأضاف :"لا يعفي الاستغلال الجنسي أو اغتصاب أي شخص، ما زال عليك اتخاذ القرار".
ونظرا لأنها لم تعترف بالإدمان الجنسي في التحديث الأول لقائمة التصنيف العالمي للأمراض منذ تسعينيات القرن الماضي، فقد اعترفت منظمة الصحة العالمية للمرة الأولى بألعاب الفيديو كإدمان، وأدرجتها على القائمة إلى جانب إدمان القمار والمخدرات مثل الكوكايين.
وقد جرى تفعيل الوثيقة، خلال اجتماع جمعية الصحة العالمية في جنيف، اعتبارا من أول يناير الماضي.
-
بي بي سي، منظمة الصحة العالمية